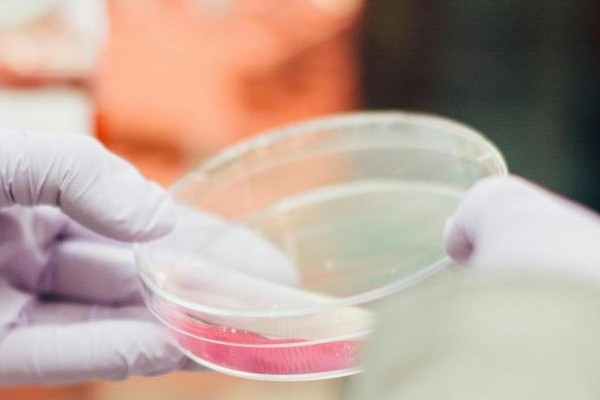

Consumers who buy a bag of lettuce expect to find a clean product with a reasonable shelf life and no health risks. Processors need to meet this need without using excessive amounts of water and, in many countries, without using resources such as chlorine. Sormac investigated to what extent UV-C can disinfect washing water in its laboratory, on a pilot-scale as well as in a practical setting. The results are promising, as long as UV-C is used correctly.
UV-C is ultraviolet light that lies outside the spectrum that can be observed by humans. The germicidal effect is the highest between 240 and 280 nm. At this wavelength, the light disrupts the DNA of micro-organisms, such that they can no longer reproduce. These properties make UV-C extremely suitable for disinfecting water.
Measuring is knowing
The test results are unequivocal: the microbiological contamination in washing water with UV-C disinfection is more than 2 log (about 99%) lower than the contamination in washing water without UV-C disinfection, see graph.

The microbiologically cleaner washing water also has a substantial positive impact on the washed end product. A reduction of approximately 1.5 log (some 96%) was measured in a 2-step washing process that involved UV-C only in the second washing cycle, shown in the graph below. Without using UV-C, the reduction is no more than approximately 65%.
Using UV-C disinfection has three benefits for processors. It reduces the probability of cross-contamination where pathogens are transferred from one product to another. Secondly, it extends the product's shelf life because it is microbiologically cleaner. Finally, UV-C disinfection offers a financial saving because less fresh water is needed.
For more information:
Sormac B.V.
Tel: +31 (0)77 351 84 44
[email protected]
www.sormac.nl